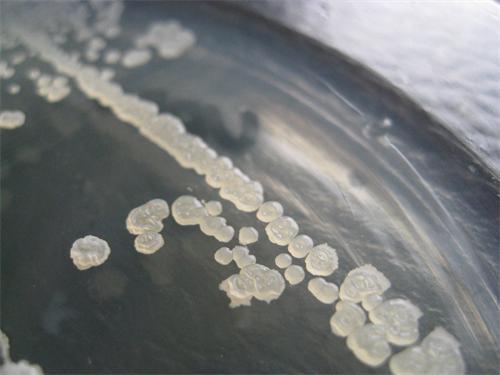
枯草芽孢杆菌

枯草杆菌圆球体图片

枯草芽孢杆菌
图片尺寸500x562
枯草芽孢杆菌价格枯草芽孢杆菌河南君安查看
图片尺寸650x571
枯草芽孢杆菌有效活菌数1000亿g顺丰包邮
图片尺寸380x380
枯草芽孢杆菌的特点 枯草芽孢杆菌的在肉鸡生产中的应用和作用
图片尺寸662x412
神奇的枯草芽孢杆菌
图片尺寸640x840
枯草芽孢杆菌粉
图片尺寸480x360
枯草芽孢杆菌
图片尺寸960x1600
枯草芽孢杆菌
图片尺寸900x697
枯草芽孢杆菌水产净水
图片尺寸750x750
枯草芽孢杆菌
图片尺寸600x444
枯草芽孢杆菌全方位分析及市场前景展望_天津开发区坤禾生物技术有限
图片尺寸3771x1355
枯草芽孢杆菌30斤水放多少克 建议收藏学习
图片尺寸640x643
发酵菌剂 单菌系列_山东潍坊生益生物饲料有限公司
图片尺寸800x600
枯草芽孢杆菌畜牧用河南君安在线咨询枯草芽孢杆菌
图片尺寸650x488
大肠杆菌,显微镜_高清图片_全景视觉
图片尺寸794x539
枯草芽孢杆菌-菌号atcc6633
图片尺寸850x850
枯草芽孢杆菌
图片尺寸501x501
枯草芽孢杆菌
图片尺寸500x375
左图为显微摄影的枯草芽孢杆菌.
图片尺寸300x293
营养和空间位点的竞争枯草芽孢杆菌对植物的作用主要体现在以下几个
图片尺寸390x277